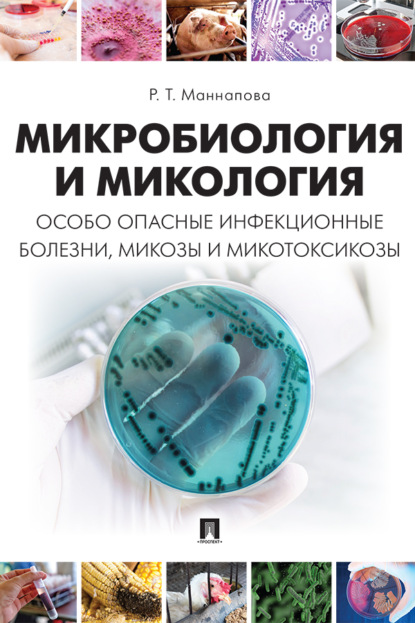
img
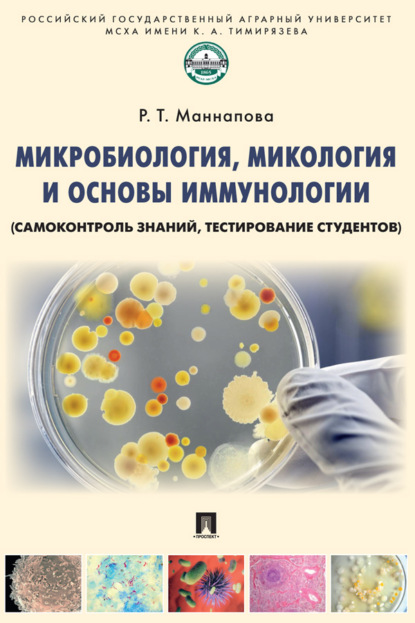
img

Р. Т. Маннапова - Микробиология, микология и основы иммунологии

Учебник состоит из восьми разделов. В нем изложены методы морфологических, физиологических исследований микроорганизмов, серологических, иммунологических и молекулярных методов диагностики. Книга содержит подробный материал о возбудителях особо опасных инфекционных болезней, микозов и кормовых микотоксикозов. Разделы составлены и изложены по единому плану. По каждой теме представлена теория вопроса, описаны материалы и оборудование, методика выполнения. Даны задания для самостоятельной работы и вопросы для контроля знаний. Ко всем инфекционным болезням, микозам и микотоксикозам в разделе 8 приведены схемы лабораторной диагностики и специфической профилактики. Представлен раздел микробиологии продуктов животного происхождения и кормов, в котором описаны вопросы их микробиологической контаминации и анализа. В разделе санитарной микробиологии предложены методы бактериологического исследования воды, почвы и воздуха. В учебнике дана подробная характеристика вопросам превращения микроорганизмами соединений углерода и азота. В конце книги приведен терминологический словарь, сведения об основоположниках микробиологии и иммунологии и лауреатах Нобелевской премии. Предназначен для подготовки специалистов с учетом требований программы ФГОС ВО по направлению 36.05.01 «Ветеринария», а также магистров и бакалавров по направлению 36.04.01/36.03.01 «Ветеринарно-санитарная экспертиза».